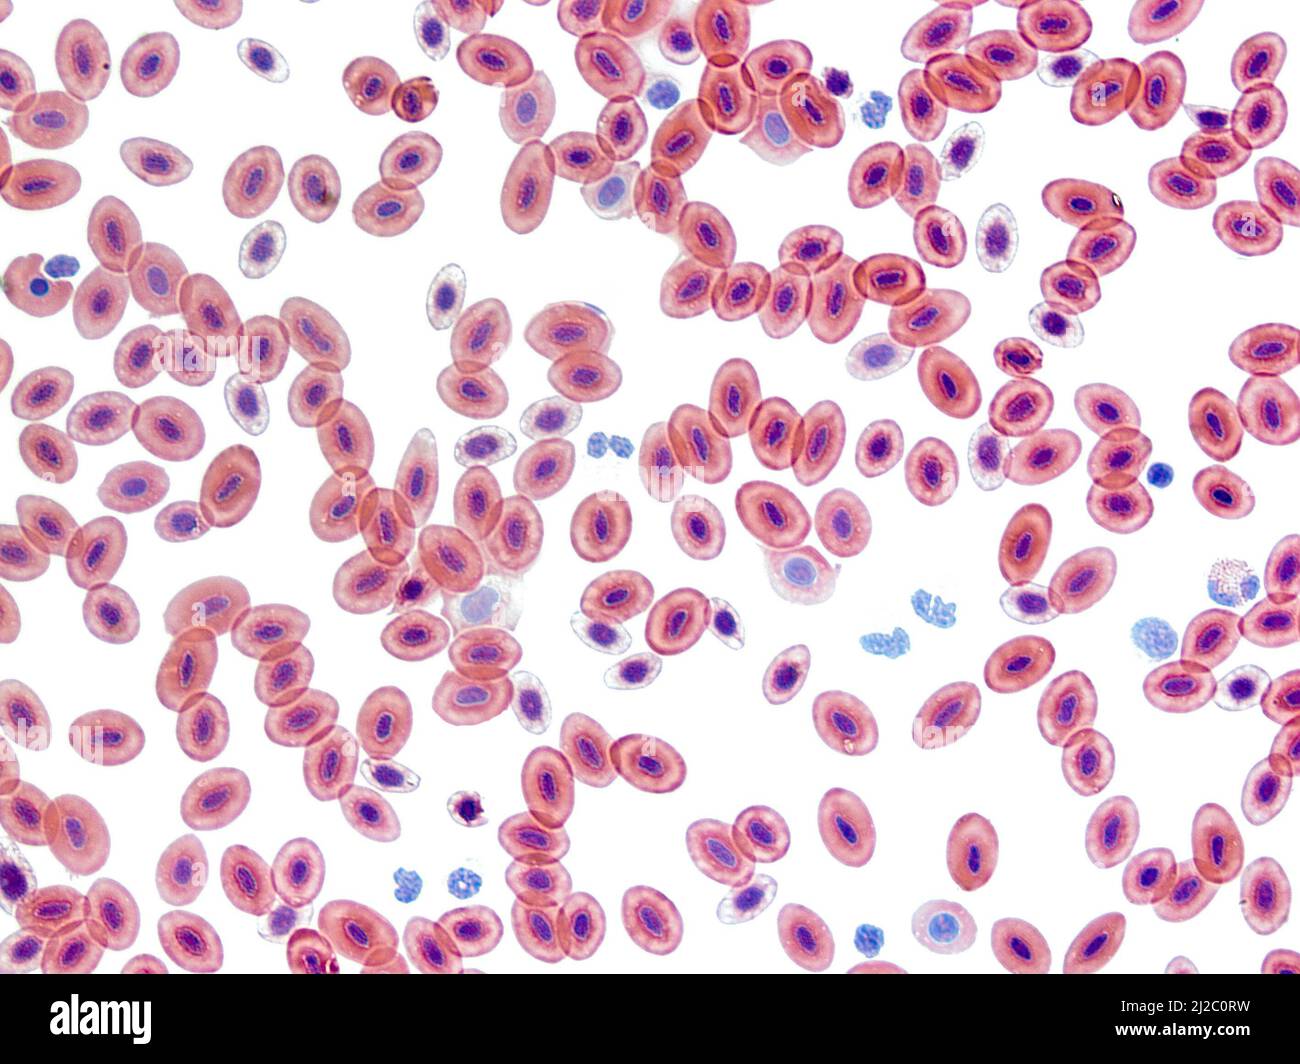
Froschblut, Lichtmikroskopie. Im Gegensatz zu den Erythrozyten von Säugetieren (rote Blutkörperchen) behalten reife Frosch-Erythrozyten ihre Kerne. Vergrößerung: X400. Stockfoto

Schnellfilter:
Red cell Stockfotos & Bilder

RFP4DX79–Menschliche Blutzellen unter dem Mikroskop. Hohe vergrößerte Abstrich von roten Blutkörperchen im Blut. Körperflüssigkeit in den Menschen. Körper Anatomie. Close Up.

RMKYYK4J–Gefängniszellen im Inneren des Roten Kreuzes Camp Museum, Nis, Serbien, von den Nazis während des Zweiten Weltkriegs nahm als Durchgangslager.

RMAGMX84–Kissen Sterne Culcita Novaguineae Haut Textur Small La Laguna Puerto Galera Mindoro Philippinen

RM2JTA90M–In der nördlichen Stadt Sapa benutzt die Frau des Stammes der Roten Dao, Vietnam, ihr Mobiltelefon.

RMB1ABAR–Rote Telefonzelle Zellen in London, England. Sie sind für viele ein archetypisches Symbol des Landes.

RF2C2FXEG–Rote Blutkörperchen auf weißem Hintergrund.3 D-Modell aus Plastilin. Hämhoben ist das Protein in den roten Blutkörperchen. Es transportiert Sauerstoff.

RFJYFY5E–Alten roten Telefon Zelle mit Schreiben e-mail + Text + Telefon, St Neot, Bodmin Moor, Cornwall, England, Vereinigtes Königreich

RF2E21X6B–Ein rot-weißer Zellenturm und großes Schild für Mobilfunkunternehmen in Mexiko mit einem klaren blauen Himmel unterstützt

RFACJB5A–Red Fuel Cell Bus und Taxi auf die London Street. Die grüne Energie getankt Fuel Cell Bus hat Bewegungsunschärfe
RF2J2C0RW–Froschblut, Lichtmikroskopie. Im Gegensatz zu den Erythrozyten von Säugetieren (rote Blutkörperchen) behalten reife Frosch-Erythrozyten ihre Kerne. Vergrößerung: X400.

RMDP35MM–Frau rot Yao ethnischen Minderheit sprechen auf Handy an Handwerk stand, Longsheng (Longji), Guangxi, China

RF2E4M2ME–Blick in Gefängniszelle Block Landung viktorianischen britisch Englisch Gefängnis Das Hausbett im Zimmer schloss die Sicherheitszimmer ab Alte neue Kategorie A B C

RMBA2WWC–Deutschland Kellner-Bayern Zelle Kirche Detail Zugspitzmassiv Morgen rot Bayern Dorf platzieren Kirchturm der Pfarrkirche Berge

RFE0A88D–Zellbiologe hält ein Fläschchen mit Stammzellen, die in roten Nährmedium kultiviert, Krankheiten zu untersuchen

RFT8PDAH–Labor Blutprobe oder Lab Tests Proben von Blut oder eine rote Lösung mit einer Pipette und ninty sechs gut cell Fach

RFP0NWWX–Ansicht von oben auf die junge Frau Hände, mit roten Nägeln, Holding weißen Smart Phone. Schwarzer Bildschirm wählen Sie Ihr Bild oder Text hinzufügen.

RFW4GFKN–Menschliche Zelle Forschung, weibliche Zellbiologe Prüfung eine Flasche mit Stammzellen, in rot Nährmedium im Labor kultiviert

RMTW6546–Lansing, Michigan, USA - 18. Juni 2019 - Michigan Lehrer sammelten am State Capitol zu fordern, dass der Gesetzgeber die Finanzierung für den öffentlichen educa

RM2JF14BK–Flagellaten der Geenera Amphidinium (gelb) und Diplopsalis (rot) zusammen mit einer einzigen Kieselalgenzelle und einer Cyanobakterienkette. Probenentnahme

RF2K9CNH8–Weißer roter Karton mit Zellenmuster als Hintergrund, hellrote Oberfläche für die Feiertagsdekoration

RF2CCF5GY–Der Winkel hier schaut vom Boden eines Funkturms nach oben. Die roten Kontraste gut gegen den Himmel und die Wolken helfen, den Hintergrund Pop.

RMH9X8A2–Mann im roten Pullover, spricht auf Handy, zu Fuß durch Säulen und Bögen, Plaza de Armas, Arequipa, Peru

RFG1F083–Draufsicht von Kommunikations- und Speichergeräten mit Computer-Tastatur auf Roteiche Desktop.












































































